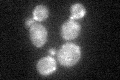
YFL047W
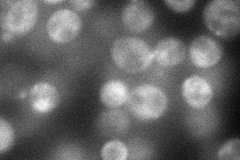
YFL047W
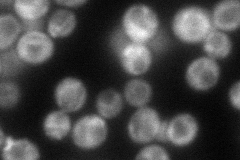
YFL047W
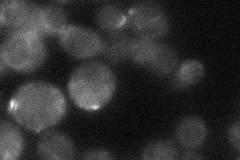
YFL047W
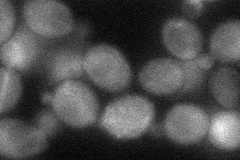
YFL047W

View description
GTPase-activating protein (RhoGAP) for Cdc42p and Rho5p
Localization:
Intensity:
Fold change:
Significance:
-
C’ GFP library in SD
cytosol, bud neck -
N' NOP1pr-GFP in SD
cytosol,punctate,bud79.381 -
N' TEF2pr-mCherry in SD
punctate,bud82.9445 -
N' NATIVEpr-GFP in SD
bud neck25.7085 -
N' TEF2pr-VC and Cyto-VN in SD
cytosol37.4513 -
C’ GFP library in SD+DTT

cytosol, bud neck22.040.65Yes -
C’ GFP library in SD+H2O2

cytosol, bud neck34.521.03No -
C’ GFP library in Starvation Media

punctateN/AN/AYes -
C’ GFP library on the background of Pup2-DaMP

cytosol, bud neck -
C’ GFP library on the background of CCT mutant

cytosol, bud neck36.60181.09325No
